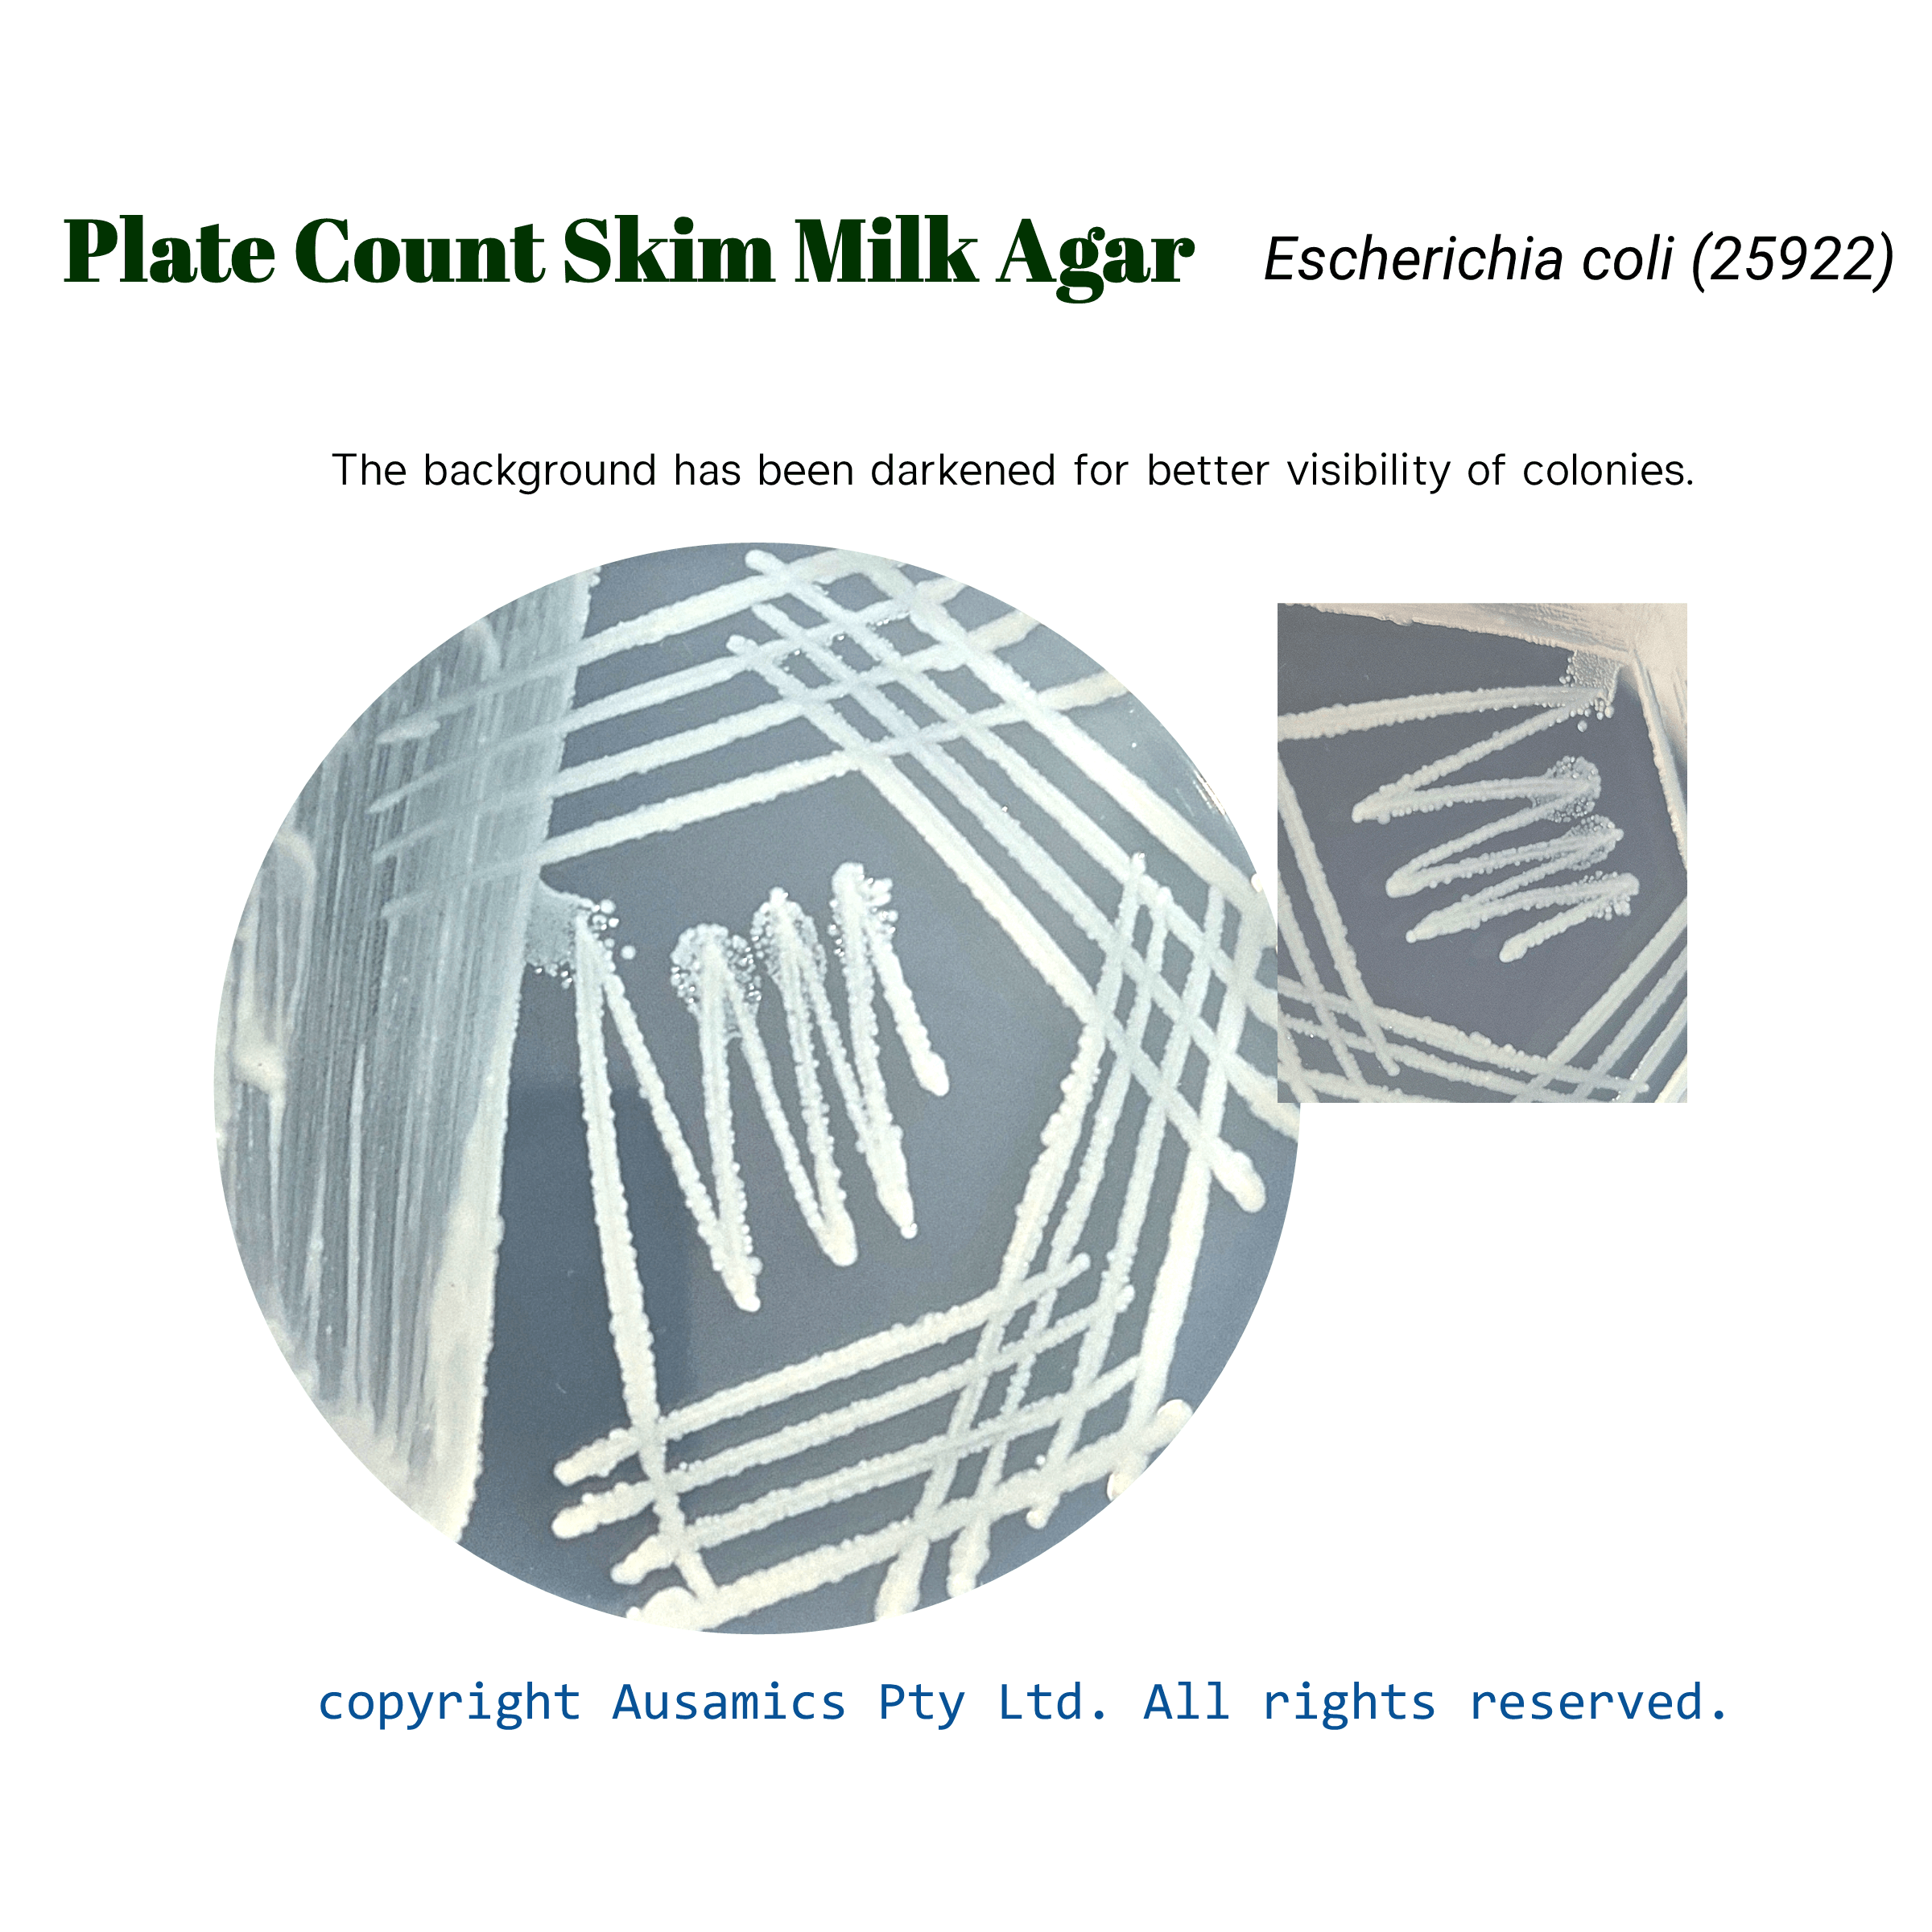
Plate_Count_Skim_Milk_Agar_Escherichia_coli

Plate Count Skim Milk Agar, PCSM
Used for determining microbial count in milk and dairy products.
Category Microbial Culture Media
Catalog Number: AS-1329
- Description
- Composition
- Quality Control
- Microbial Test Results
Plate Count Skim Milk Agar is a nutrient-rich, standardized medium that was developed especially for counting the microorganisms in milk and dairy products.
Peptone, glucose, yeast extract, and agar, indicate a balanced nutritional profile that supports a variety of microbial growth. Addition of skim milk, improve the cultivation of target microorganisms by replicating their natural environment. The dairy product matrix’s non-selective formulation makes it possible to isolate and analyze a variety of bacteria populations.
Storage
Keep the container at 15-30 °C and prepared medium at 2-8 °C.
| Composition | gr/L |
| Peptone from Casein | 5 |
| Yeast Extract | 2.5 |
| Skim Milk Powder (no inhibitor) | 1 |
| Glucose | 1 |
| Agar | 10.5 |
| Final pH at 25°C | 7.0 ± 0.2 |
| Dehydrated Appearance | Light beige, free-flowing, homogeneous. |
| Prepared Appearance | Light amber, slightly opalescent. |
| Reaction of 2.0% Solution at 25°C | pH 7.0 ± 0.2 |
| incubate at 35 ± 2 °C for 18 to 48 hours. | ||
| Organism (ATCC) | Inoculum CFU | Recovery |
| Escherichia coli (25922) | 103 -105 | Good |
| Staphylococcus aureus (25923) | 103 -105 | Good |
| Bacillus cereus (11778) | 103 -105 | Good |
| Candida albicans (10231) | 103 -105 | Good |